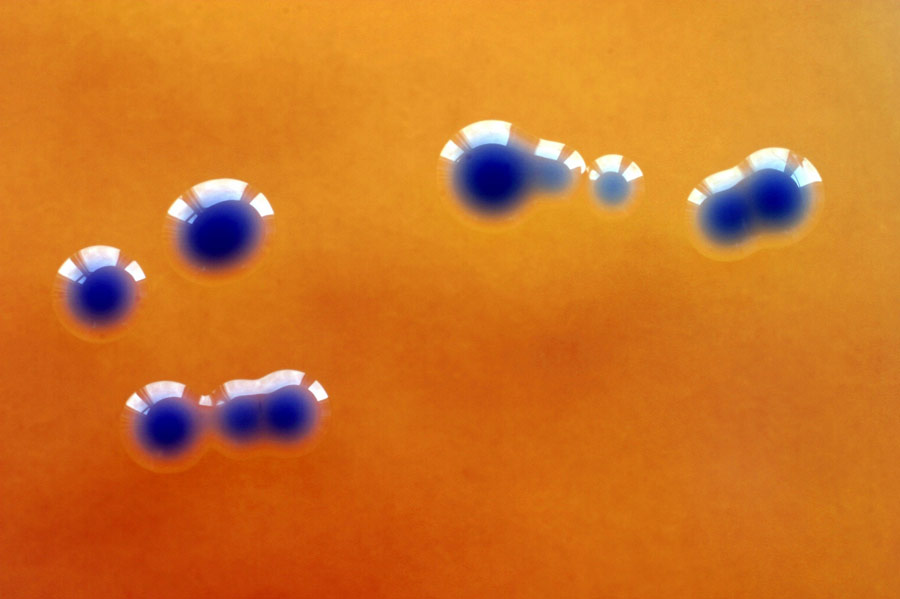

Klonieren
Forschende verwenden zum Klonieren verschiedene molekulare Hilfsmittel. Unentbehrlich sind dabei die Restriktionsenzyme (genauer Restriktionsendonukleasen), welche die DNA an bestimmten Positionen erkennen und schneiden können. Restriktionsenzyme kommen in Bakterien vor und sind mit Wachhunden vergleichbar: Sie schützen die Bakterien vor dem Eindringen von Viren. Die Restriktionsenzyme erkennen die virale DNA und zerstückeln sie in einem Vorgang, den man als Restriktion bezeichnet. Restriktionsenzyme können zwischen eigener und fremder DNA unterscheiden, denn die eigene DNA ist durch eine Methylgruppe chemisch markiert, welche wie eine Fahne funktioniert. Fremde DNA hingegen trägt diese Fahne nicht.
Restriktionsenzyme arbeiten äusserst spezifisch: Sie erkennen kurze DNA-Sequenzen und schneiden den DNA-Faden an dieser Stelle. Ein von Forschenden in Experimenten oft verwendetes Restriktionsenzym heisst Eco RI, das erste beim Bakterium Escherichia coli (E. coli) entdeckte Restriktionsenzym. Es erkennt und schneidet die Sequenz GAATTC, wobei es sogenannte klebrige Enden («sticky ends») hinterlässt (siehe Filmsequenz «Recombinant DNA Technology»). Auf diese Weise entstandene DNA-Stücke (Fragmente) können relativ einfach wieder untereinander verknüpft werden (siehe Grafik 2.1).

© Interpharma
Neben den Restriktionsenzymen sind Plasmide ein weiteres Hilfsmittel für eine Klonierung. Plasmide sind «Gen-Taxis»: Sie können fremde DNA aufnehmen und in Bakterien überführen. Bakterien, z.B. E. coli, übernehmen dann die Produktion der Gene und Proteine. E. coli Bakterien sind die Hauptversuchsorganismen vieler Labors und sind die am besten erforschten Lebewesen.
Damit die Klonierung funktioniert, wenden Forschende einen Trick an: Die verwendeten Plasmide besitzen zusätzlich ein Gen, das den Bakterien, die das Plasmid aufnehmen, eine Resistenz gegenüber dem Antibiotikum Ampicillin verleiht. Diese Resistenz wird sich später als wichtig erweisen.
Das Restriktionsenzym Eco RI zerschneidet in unserem Versuch die menschliche DNA, die wir aus der Speichelprobe gewonnen haben. Dadurch entstehen tausende DNA-Stücke – eines davon enthält das gesuchte Insulin-Gen. Mit den gleichen Enzymen zerschneiden wir auch die bakteriellen Plasmide. Aufgrund der klebrigen Enden können wir die einzelnen Stücke wieder zusammenführen. Viele Plasmide werden nichts aufnehmen, viele nehmen menschliche DNA auf und einige wenige werden das gesuchte Insulin-Gen aufnehmen. Alle Plasmide werden dann in E. coli-Bakterien eingeschleust.
Nun verteilen wir alle Bakterien auf einer Platte mit Nährmedium, auf dem Bakterien prinzipiell aber nicht wachsen können, weil die Platte das Antibiotikum Ampicillin enthält. Mit diesem Schritt teilt sich die Spreu vom Weizen: Alle Bakterien, welche ein Plasmid aufgenommen haben, können auf der Platte wachsen und eine Kolonie bilden, da das Plasmid sie resistent macht gegenüber Ampicillin. Die Bakterien vervielfältigen sich und mit ihnen das gewünschte Insulin-Gen.
© istockphoto
An diesem Punkt haben wir durch die Klonierung tausende von menschlichen DNA-Stücken geschaffen und nicht nur solche, die uns interessieren. Der nächste Schritt, die Durchmusterung aller Kolonien, auch «screening» genannt, ist sehr aufwändig.
Wie können wir aus all den tausend Klonen denjenigen finden, der unser Insulin-Gen trägt? Wenn wir bereits einen Teil der DNA-Sequenz des Insulin-Gens kennen, dann können wir ein etwa 30 Basenpaare langes mRNA-Stück herstellen, welches wie eine Sonde an die Insulin-Gensequenz andocken wird. Diese Sonde ist radioaktiv oder mit Fluoreszenz markiert, damit wir feststellen können, bei welchen Klonen sie andockt. Dank dieser Sonde finden wir jenen Klon, der unser Insulin-Gen enthält (siehe Grafik 2.2). Mit dieser Technik können viele weitere Gene geklont werden, z.B. für Wachstumshormone und Interferon, Genprodukte, die ebenfalls als Medikamente eingesetzt werden.

© Interpharma
Damit ist die Genklonierung erfolgreich abgeschlossen und es wird ersichtlich, warum dazu Bakterien verwendet werden und keine höheren Organismen: Höhere Organismen pflanzen sich sexuell fort. Sexualität hat für diese Lebewesen den Vorteil, dass das Erbgut neu kombiniert wird und dass daraus neue Individuen mit neuen Eigenschaften entstehen. Das schafft in der Evolution Vorteile. Für Forscherinnen und Forscher ist diese genetische Neukombination aber störend, denn damit könnte auch das Insulin-Gen verändert werden.
Forschende müssen mit Tieren arbeiten, die genetisch identisch sind: nur Klone reagieren in einem Experiment immer auf die gleiche Weise. Möchten Forscherinnen und Forscher ein Medikament testen, so verwenden sie stets Mäuse des gleichen Stamms. Solche Mäusestämme werden mithilfe der Inzucht gezüchtet oder es werden dazu eng verwandte Tiere miteinander gekreuzt.